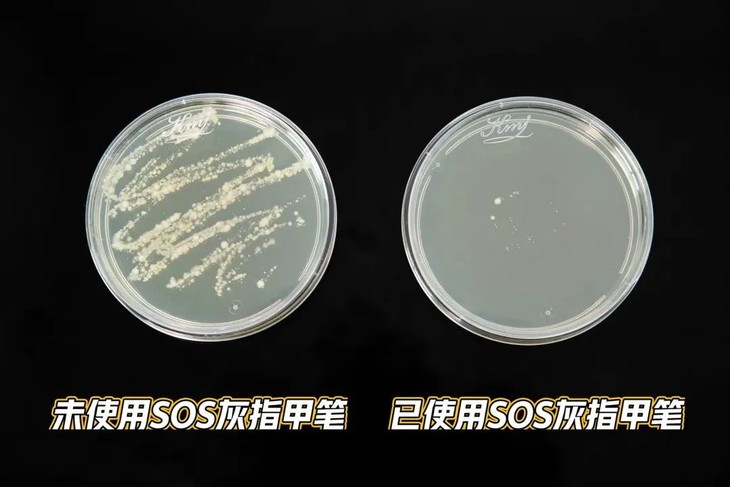

前段时间朋友在洗脚时,突然发现大拇指甲上有块灰黄色,还有些变厚,因家里有人是灰指甲,让她立马想到自己不会也有灰指甲了吧!?


跟灰指甲斗争过的人都知道,它有多顽固!古方土方泡、包,甚至是刀片割、拔指甲……罪受了那么多最后长出来的指甲还是老样子!


所以有了灰指甲一定要尽早解决!而且这些有害菌都具极强的传染性,家里人很容易接二连三的中招!

今天推荐给大家的这款风靡欧洲的SOS灰指甲修复笔。
不用包!不伤肤!不拔甲!
使用很方便,只需每天涂一涂,
不影响日常走路!安全去灰甲!

像日常的甲板脆裂、甲板增厚、甲板浑浊、甲板脱落等等都可以帮助修复。


德国进口SOS灰指甲修护液
击退灰甲,重现健康亮甲
快速吸收、速干
点击下方抢购
1
德国国民品牌,热销欧盟
口碑好,信得过
SOS是德国国民护理品牌,始创于1993年,专攻家庭护理等产品,旗下护理产品经常是断货王。


拥有德国质量体系认证证书,在2016年还斩获了德国品牌大奖。实力真的牛!


在欧洲各大品牌连锁商超都能看到SOS的身影,实打实的爆销人气王。

网上都要夸爆了!不管是灰甲还是指甲增厚,再或者是普通的指甲损伤,都可用!

2
无需拔甲、拒绝反复
击退灰甲,重现健康亮甲
灰指甲之所以顽固,原因就在于细菌清除不彻底,对付灰指甲的第一步就是把细菌清除干净!

而SOS火了30多年,帮助那么多有灰指甲的伙伴,全靠这解决真菌的实力。添加的成分都是一等一的高手——尿素、乙氧基、戊二醇。


它们就像战士一样,冲进厚厚的指甲内部,一点一点地清除隐藏在深层的真菌,修复受损组织,提供新生能力。


手指呈灰白色,又厚又硬,甲液渗入甲根,长出的新甲和健康的指甲一样!

对真菌的作用可是验证过的!大肠杆菌、金黄色葡萄球菌、统统有高达99%的抑制作用。

我们拿来有灰指甲朋友的鞋,效果太明显了,涂抹过SOS灰指甲液器皿里的真菌几乎都不见了。

尤其是家里老人,很容易有增生的厚甲,穿鞋总觉鞋子顶脚,指甲变薄后,就不用让脚受苦了。


▲脚趾指甲生长速度较慢,时间要更长
手上有灰甲的朋友,一定要早日使用,避免社交尴尬。


▲指甲发白变厚,是灰指甲的前期症状,要特别注意。
SOS指甲修复液里还添加了甘油等滋润成分,帮助软化指甲,不止是灰指甲指甲松脆、残缺日常也可以涂抹,新长出的指甲平滑有光泽!


亚马逊上一眼望去几乎都是好评:用不了多久就看到变化了;终于有个有用的东西了……


3
像涂抹指甲油一样简单
温和速干,快速吸收
笔刷头的设计,直接刷在指甲上就可以了,用的时候扭一扭“屁股”,透明护理液就会从刷头处出来。


均匀刷在指甲上,没有刺激感,没什么味道,反而清凉又舒服。涂抹的时候,涂满指甲和甲床边的皮肤,渗透性会更好。

大概2分钟左右就干了,穿袜子、鞋子去上班也完全没影响。

可以早上出门前,晚上洗完澡后各涂一次。慢慢地可以看到灰指甲变平滑了, 黄色的指甲也有了一丝粉嫩。

每天1-2次,也就1天4分钟左右!一定要坚持使用。原装进口,带防伪码!
别犹豫,现在在某平台的官方价格是159/支,小贵小贵。今天我们直接从品牌方砍价,拿到一批团购价,不到百元,先到先得!


德国进口SOS灰指甲修护液
击退灰甲,重现健康亮甲
快速吸收、速干
点击下方抢购
想告别“灰黑”指甲一定要认准大品牌,早用早好,再也不用遮遮掩掩或是担心传染给家人啦~
